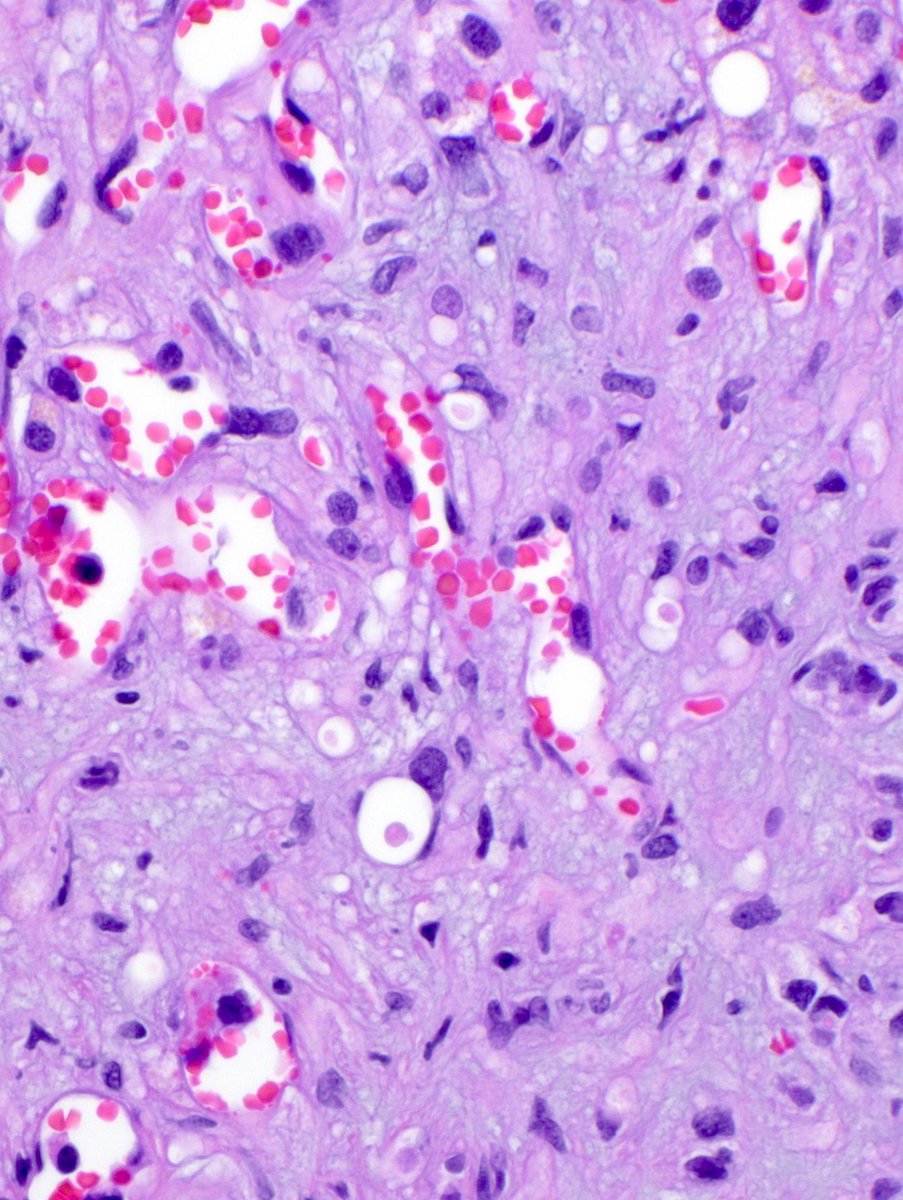
Jerad Gardner, MD tweet media

It has been an amazing learning opportunity!
I invite all of you to explore the content, which now includes over 550 cases!
worldtumorregistry.org
English
Beatriz Fuga Rossi Teixeira
588 posts

@beatriz_frt
Pathologist at Oncoclinicas&Co, focused on ENTpath, Cytopath and Neuropath